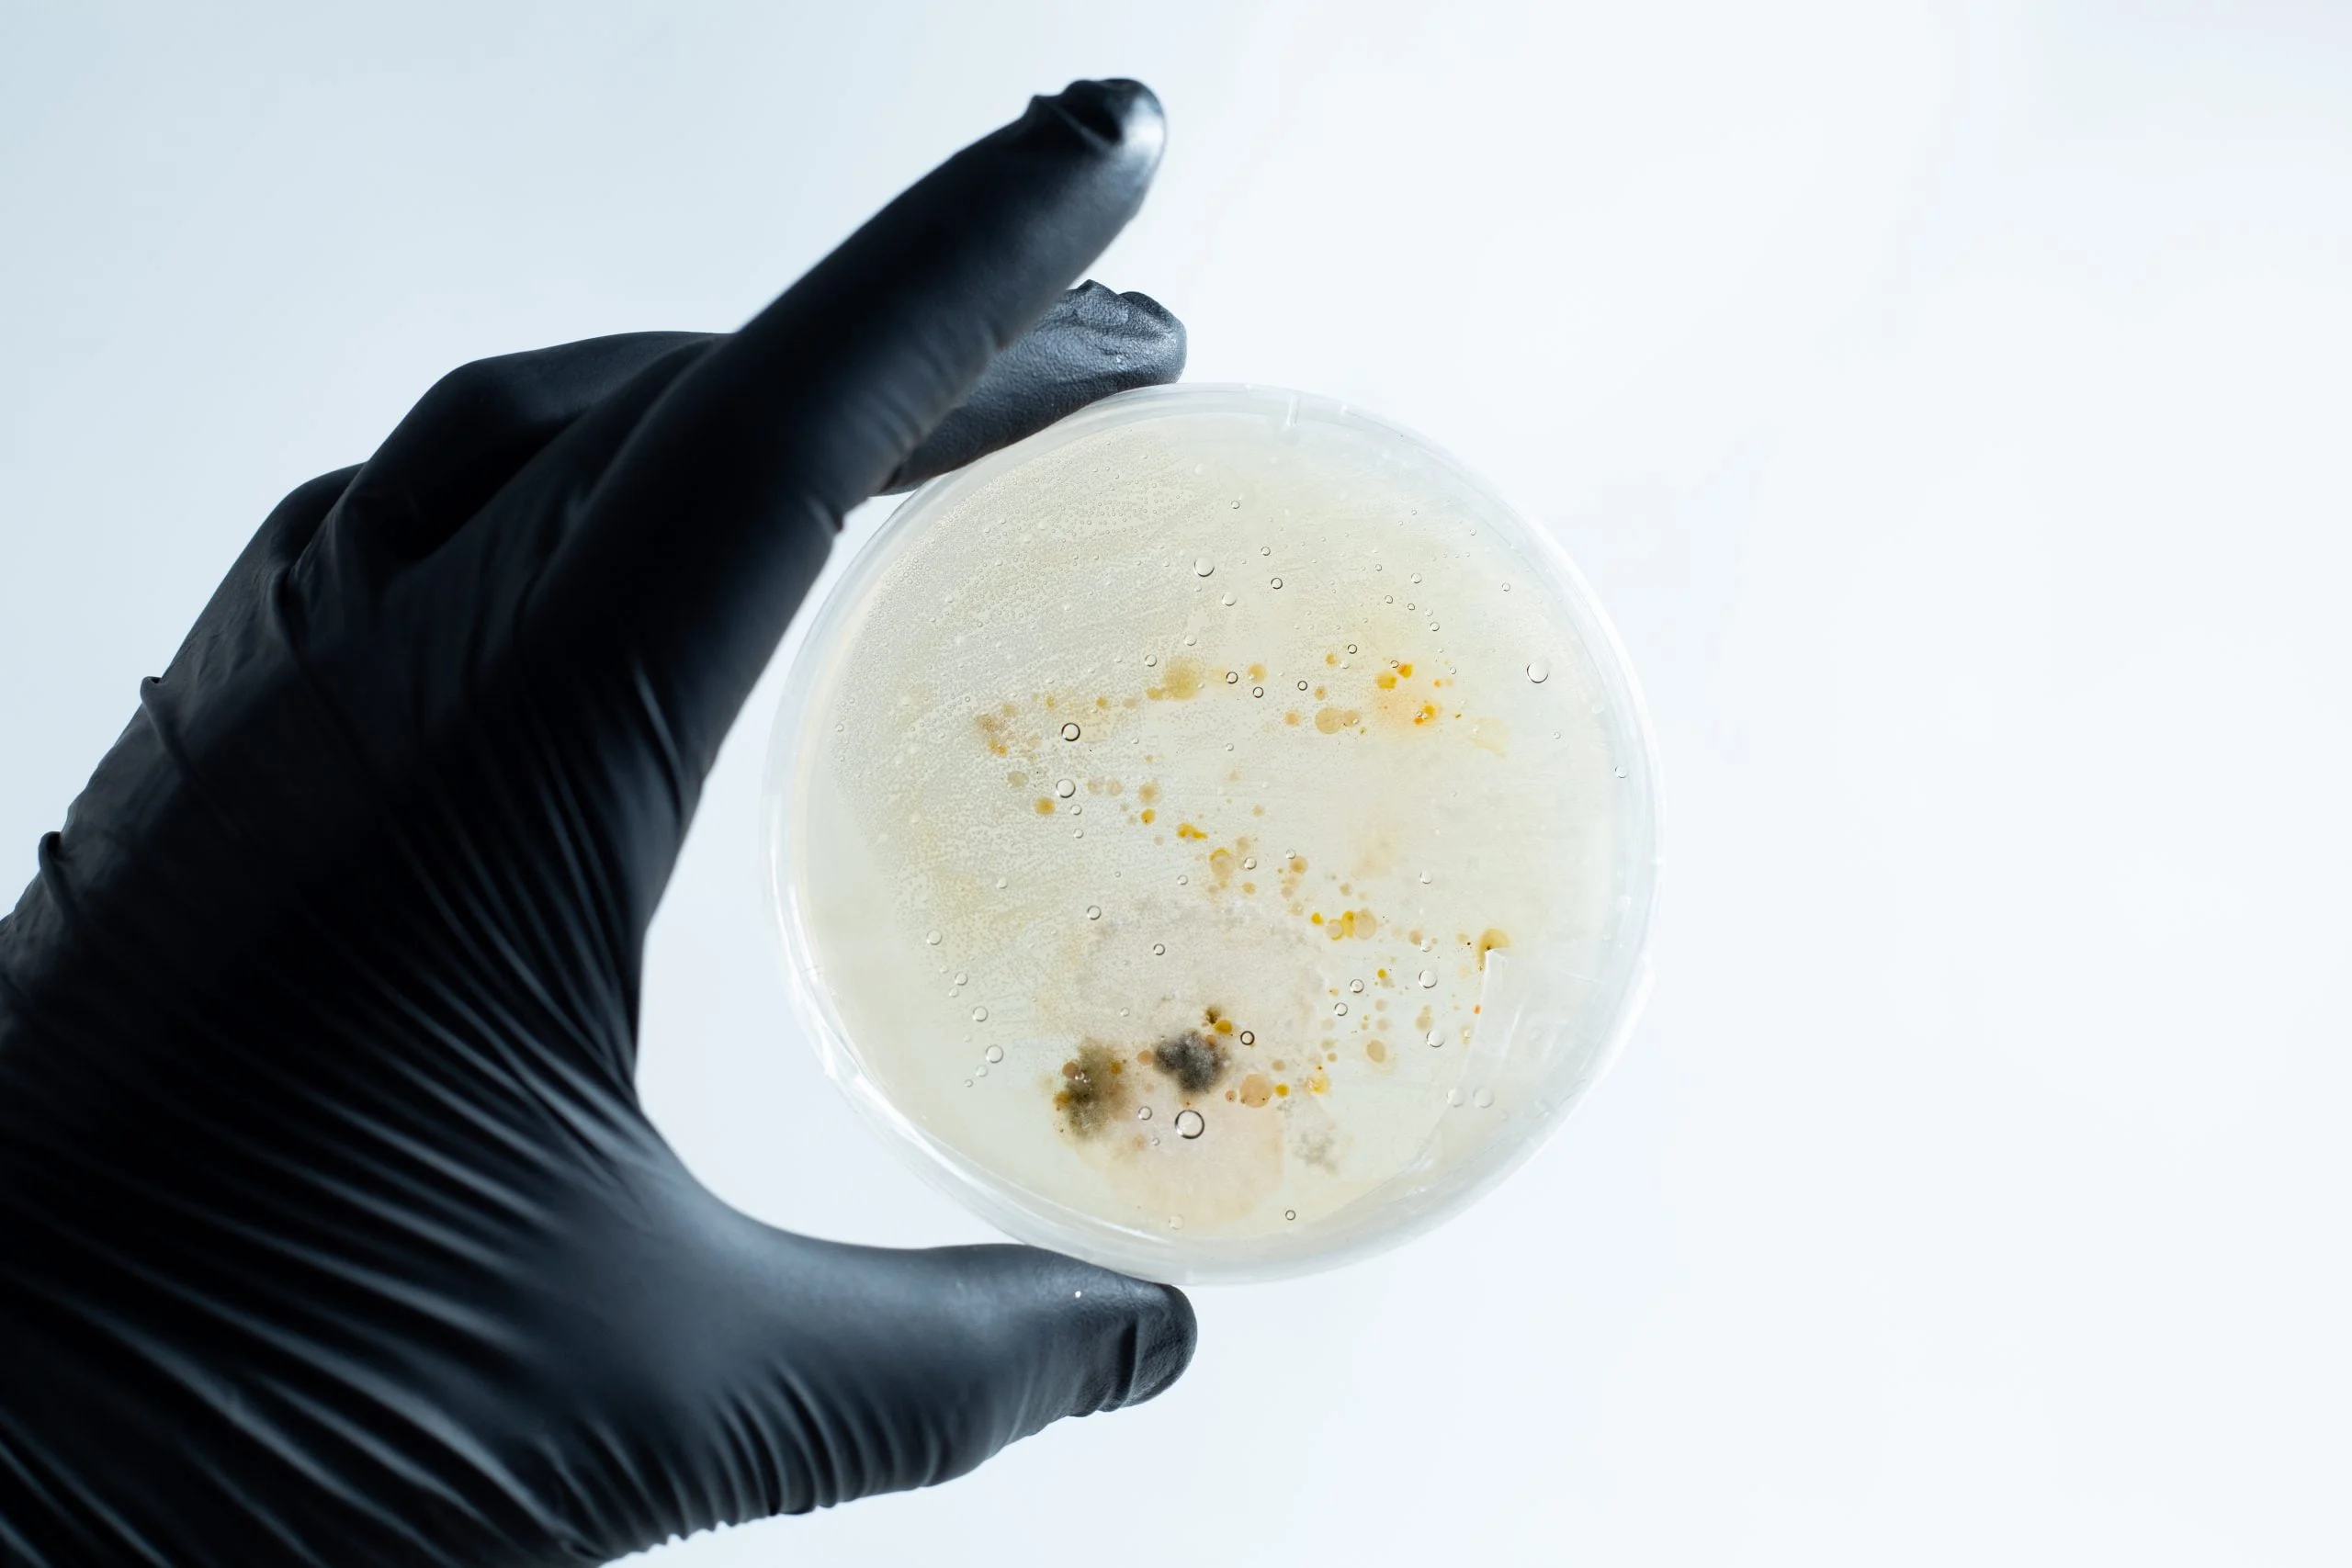
A hand in a black glove holds the Agar petri dish MEA School Science Fun Project Kit with mould and bacterial colonies—ideal for exciting school experiments—against a white background.
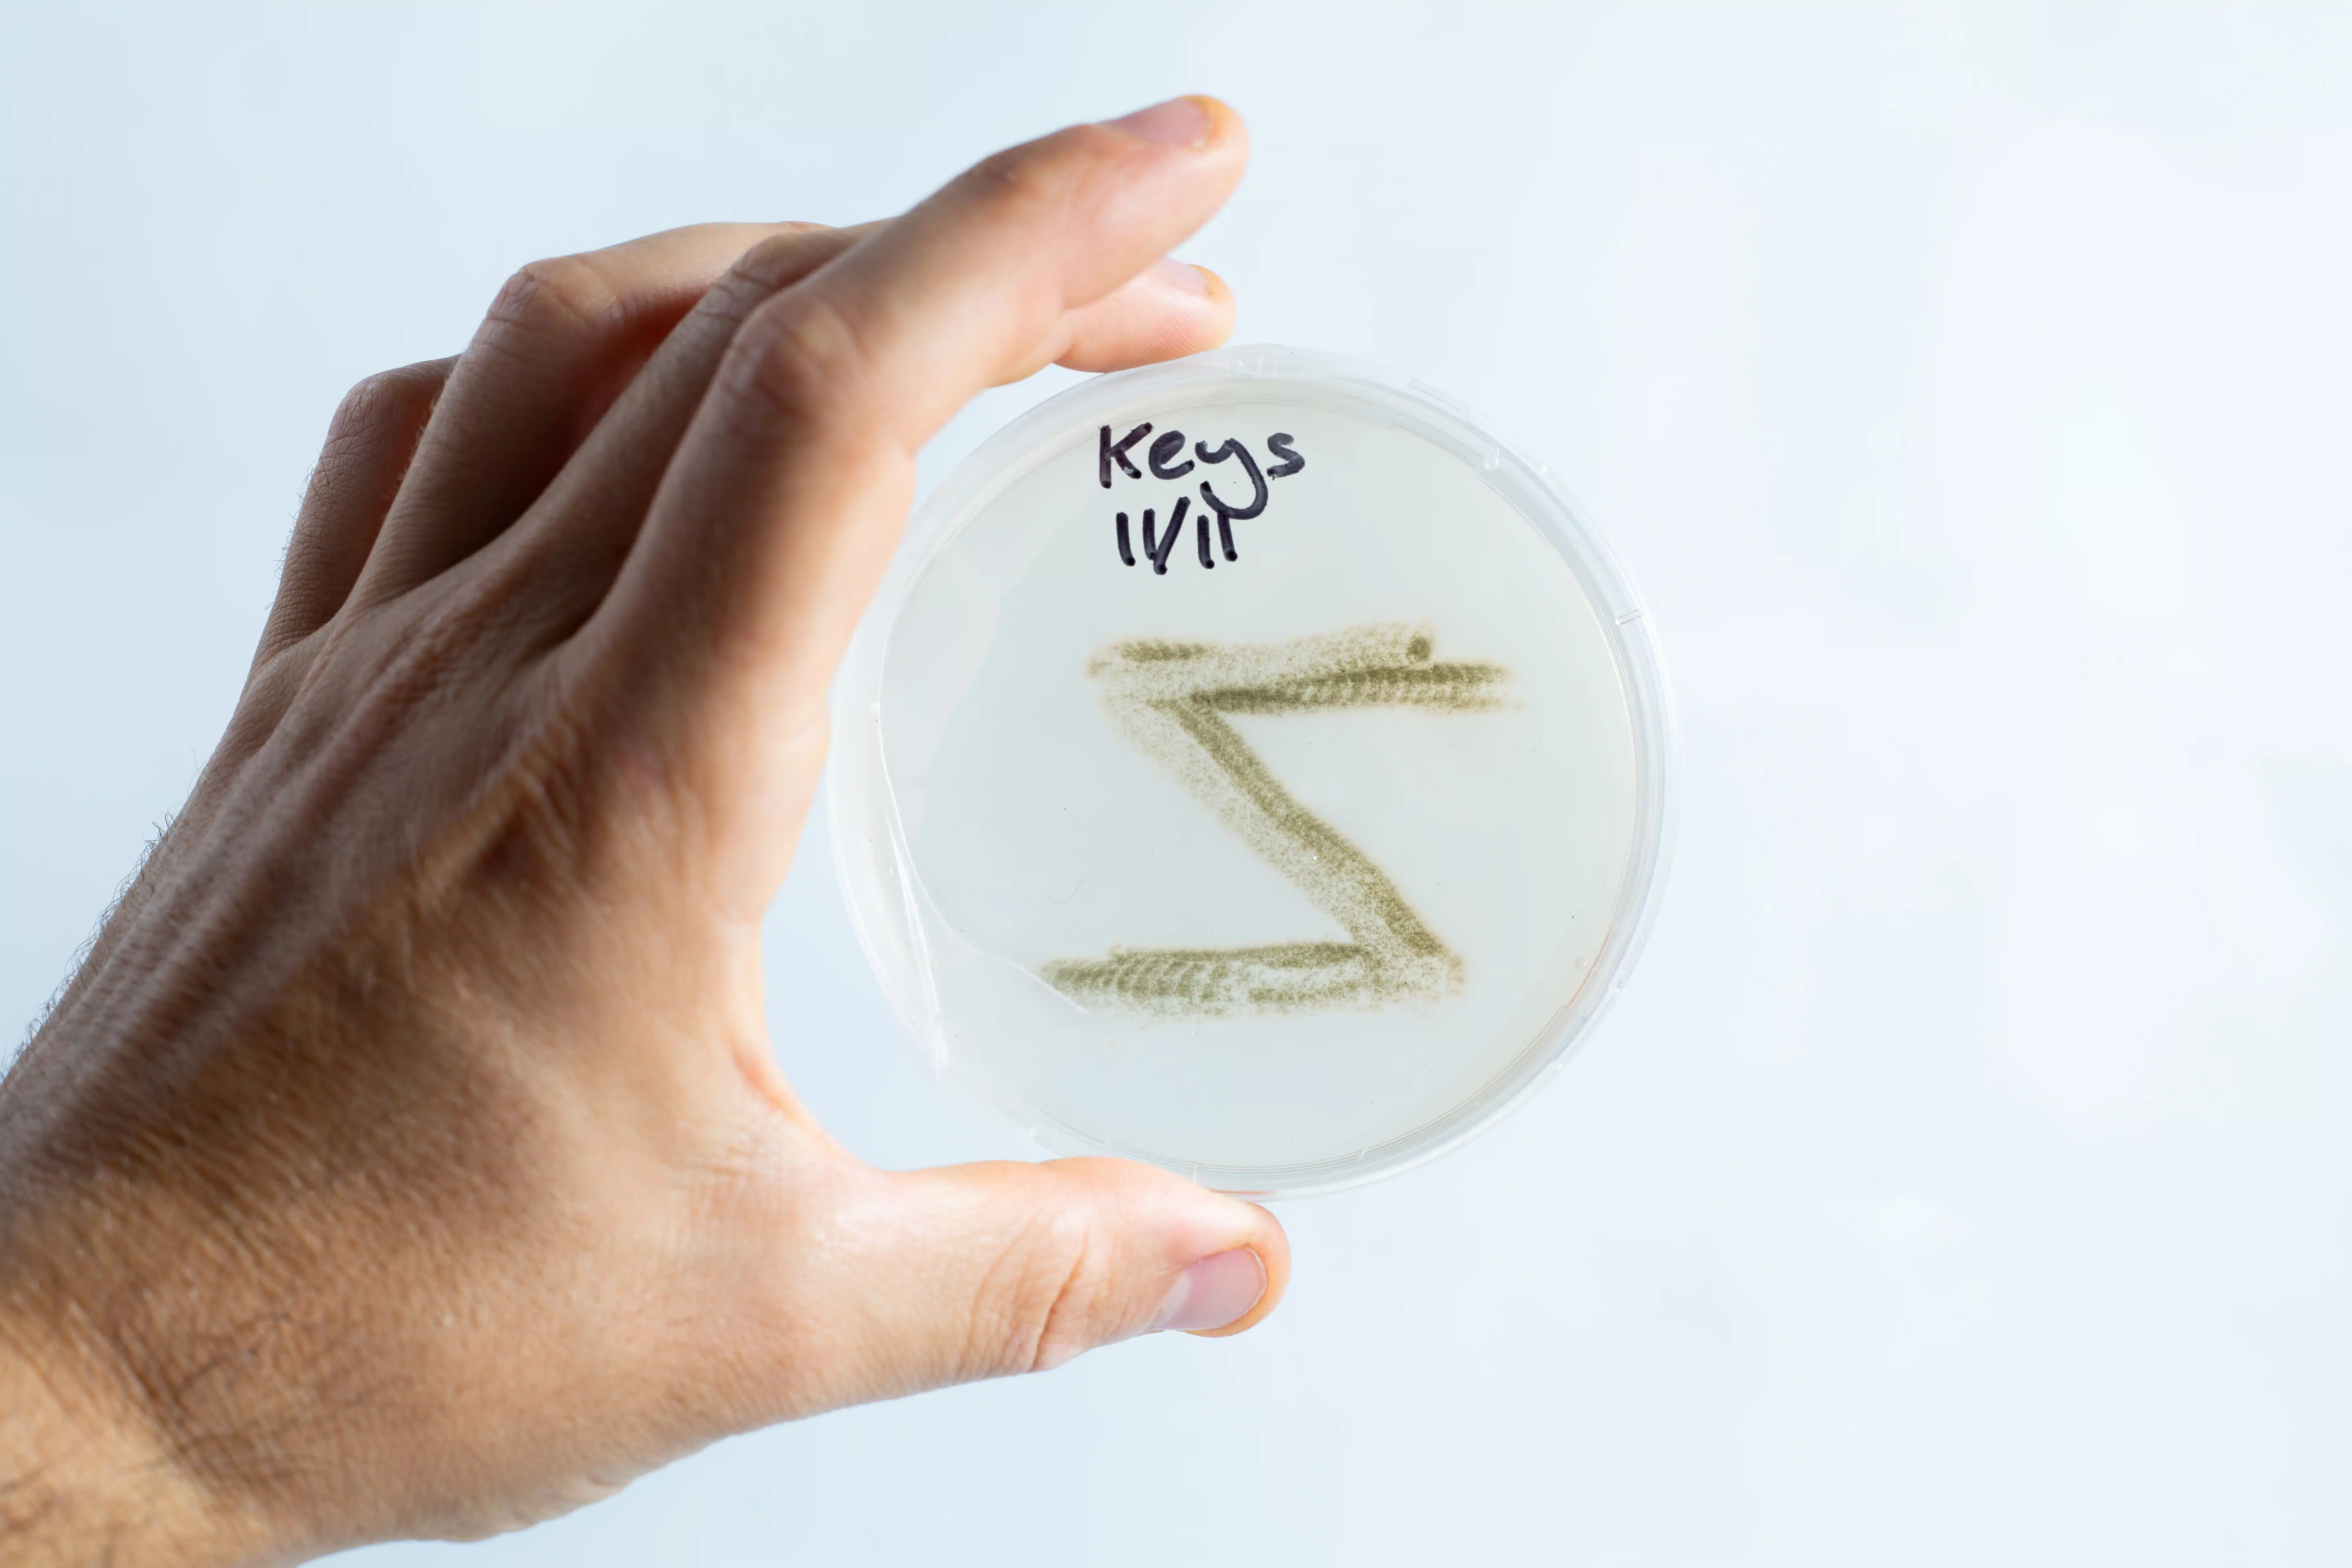
A hand holds an agar Petri dish MEA from the School Science Fun Project Kit, labelled “Keys 11/11,” displaying a fuzzy pattern—great for classroom experiments.

Description
Please be advised that during the months of December through February, shipping agar plates can be particularly challenging due to environmental factors. When the temperature of the package exceeds 40°C, the plastic wrap or wax parafilm used for sealing may melt, shrink, or otherwise be compromised due to heat. This can increase the likelihood of contamination.
A bubble or condensation on any of the plates is not a cause for concern and does not affect the product’s quality.
If you encounter contamination, please send us a clear photo of the affected plates, along with the number of plates affected and your order number. A refund will be issued upon verification of the issue.
Please note that we are unable to offer replacements, as the same environmental conditions may lead to similar issues. We appreciate your understanding and cooperation during this period.
Microbe Explorer: Your Kids’ Passport to a Tiny, Wondrous World!
Unveil the mystic microscopic world to your budding scientists with our Microbe Explorer Kit – a perfect blend of fun, learning, and invaluable life lessons. Amidst a post-Covid era, understanding the existence and behaviour of microbes has never been more crucial. This kit is not just an array of science tools but a thrilling adventure waiting to unfold right in your kitchen, classroom or backyard!
What’s Inside the Box:
- 10 Ready-To-Use Petri Dishes: Pre-poured with nutrient-rich Malt Extract Agar, sealed snugly, awaiting the tiny guests.
- 10 Sterile Swabs: Your kids’ magic wands to transfer the invisible, curious creatures onto the agar beds.
- 10 Parafilm Strips: To keep the micro-invaders securely inside, gearing up for the big reveal.
- A User-Friendly digital Guide: Simple, engaging instructions to kickstart their microbe-hunting journey(Written for kids, parents ensure safety is followed).
What’s not included:
- Gloves
- Mask
- Hand sanitizer
Plate Shelf Life and Storage
The optimal shelf life for plates is 30-45 days. Order plates as needed, as they cannot be stored indefinitely, even in their original packaging. While most plates can last for months, their ideal shelf life is 30 days.
Usage and Contamination
Plates may remain usable beyond 30 days if uncontaminated. If contamination occurs in one plate, it doesn’t affect others in the pack. Discard contaminated plates and use the rest as normal.
The presence of a bubble or condensation in any of the plates is not a cause for concern.
Long-term Storage
Extended storage may cause plates to lose moisture, becoming stiff and papery. Use plates only if they remain gelatinous and uncontaminated. Discard any that become stiff or papery, as they can no longer support organism growth.
Refund Policy
For damaged or contaminated plates upon delivery:
• Contact us within 30 days of the ORDER date
• Provide photos for refund requests
• No replacements are offered; only refunds
Storage Guidelines
Before inoculation:
• Store in a cool, dry place (e.g., cupboard)
• Avoid refrigeration to prevent condensation
• Place upside down to minimize condensation
After colonization:
• Refrigerate when at least 60% colonized
• Label (date and species) and put in zip-lock bags for storage
• It is best to keep it in the vegetable compartment of the fridge
Remember: The packaging sleeve is not a sterile seal. Proper storage is crucial for maintaining plate quality.
Enlightening Experiments: From the harmless microbes on their toys to the vigilant ones on the doorknobs, let them explore, grow, and observe!
Safety First: No need to juggle hot agar or other risky stuff. Our kit is designed to keep the safety of young scientists at the forefront.
Science Fair Ready: Our sterile and sturdy setup nurtures the microbes and your child’s chance to shine in the science fair!
Foster Curiosity and Responsibility: Through hands-on experimentation, kids will not just satisfy their scientific curiosity but also develop a keen understanding of hygiene.
Natural and Safe Ingredients:
- Malt Extract: A sweet invite for microbes with its high maltose content, aiding their growth.
- Agar-Agar: Extracted from seaweed, it’s the perfect gelatinous base for our micro-guests, with no animal products involved!
We’re Here For You: Got questions or need more kits for a whole class or a science club? Reach out, and we’ll cater to all your microbe-exploration needs!
Dive Into the Micro World: The doorknob, the garden soil, or even the air – where will your young scientist discover the extraordinary?
Our Microbe Explorer Kit is not just a product but an enthralling experience, a lesson of life, and a spark of curiosity. So why wait? Embrace the micro-adventure and unveil the hidden microscopic reality together with your child!
Grab a kit, and let the tiny tales of microbes enchant your young explorer’s scientific soul!
Feedback is Our Stepping Stone:
We value every bit of feedback to enhance our offerings. Let’s mold future scientists with the right blend of fun and knowledge!
We offer other Pre-Poured Agar plates in our store.
Visit our blog for step by step instruction on this Swab and Grow Bacteria Growth Science Experiment